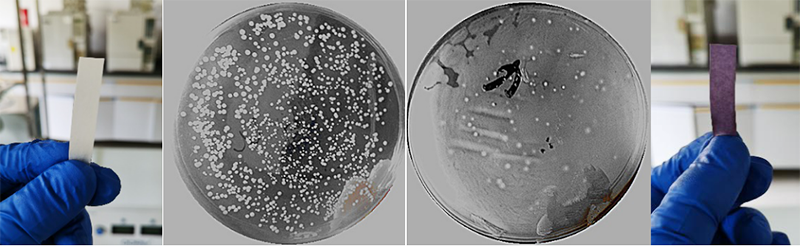

新型冠状病毒肺炎疫情发生以来,常州大学深入贯彻落实习近平总书记有关疫情防控的重要指示精神,充分发挥学科专业优势,积极组织相关课题组进行科研攻关,聚焦生物安全防控展开协同创新工作,全力打好科技防控攻坚战。
疫情期间,常州大学陈群团队的王龙耀课题组,在先进催化与绿色制造协同创新中心和国家地方联合工程研究中心支持下,基于双向透过性膜材料开发了纯水零极距电解制备臭氧装置。该装置克服了臭氧在常态下难以储存和运输的缺陷,结合限域释放技术,用于放置有贵重精密仪器和有洁净要求的实验室的杀菌防控,与腐蚀性强且会残留的活性氯、易燃易爆的乙醇等典型消毒剂相比,杀菌效果高效广谱,分解产物为氧气,无污染。
我校科研团队开发的双向透过性零极距电解技术,能将纯水高效转化为臭氧和氢气,具有原料安全易得、无电磁辐射、无氮氧化物产生等独特优势,特别适合在敏感和有洁净要求的场所应用。为进一步推动该技术的成果转化,我校积极利用高价值专利培育平台对相关技术进行了组织,形成了具有一定容量的专利池(申请相关发明专利18项,实用新型专利3项,其中发明专利已授权7项),目前已经面向企业展开了技术转移和成果推广工作。(通讯员/曹婧妤 龚婧 审核/吴荷平 彭明国 编辑/庄媛)
臭氧化处理前后KI淀粉试纸和培养皿菌落数变化对比照片

协同企业提供臭氧净化设备支援一线抗击疫情(2月20日)

不同实验室臭氧杀菌防控现场照片(左上,气熏蒸实验室整体;右上,雾化喷洒液质联用仪实验室;
左下,雾化喷洒渗透汽化实验室;右下,雾化喷洒比表面与孔隙度分析仪实验室)

